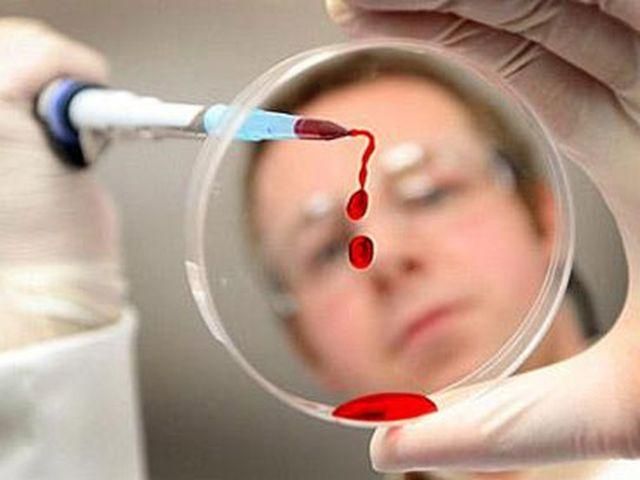
У Німеччині невідомим вірусом інфіковано вже більше 10 тисяч дітей У Німеччині невідомим вірусом інфіковано вже більше 10 тисяч дітей

"Станом на вівторок, 2 жовтня, зафіксовано 10 тисяч і 8 випадків захворювання на кишкову інфекцію", – повідомили у прес-службі берлінського Інституту вірусології імені Роберта Коха.
Вірусологи повідомили, що це – наймасштабніша в Німеччині епідемія за останні роки. За їхніми даними, перші випадки зараження були зафіксовані на початку минулого тижня, а пік епідемії припав на 26 та 27 вересня, після чого кількість нових випадків почала зменшуватися.
Як відомо, спалахи інфекції були зареєстровані у 416 навчально-виховних закладах східнонімецьких земель – Берліна, Бранденбурга, Саксонії, Саксонії-Ангальт та Тюрінгії.
За словами експертів, джерелом міг стати так званий норовірус. Водночас, місцева влада припускає, що діти отруїлися їжею з їдалень у школах та дитсадках.
Нагадаємо, раніше повідомлялося, що у Німеччині понад 6 з половиною тисяч дітей заразилися небезпечним вірусом, імовірно, кишковою інфекцією.